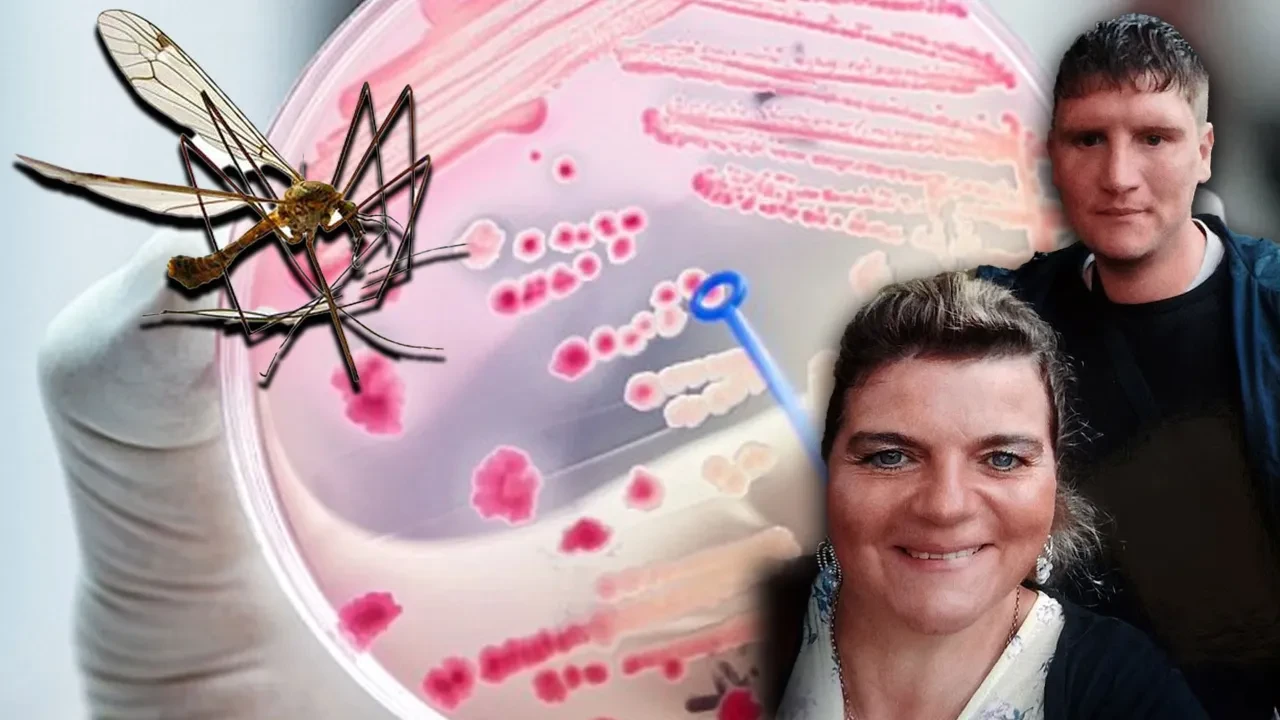

Kategoriler
UYGULAMALAR
İstanbul
İngiltere'de çiftçilik yapan 31 yaşındaki Andrew Kane, bir sinek tarafından ısırıldığını fark etti fakat umursamadı. Zamanla sineğin ısırdığı bölge yara haline geldi. Kane kolundaki kızarıklık, kaşıntı için doktora gittiğinde ise antibiyotik tedavisine başlandı.
Antibiyotikler işe yaramış gibi görünse de Kane arkadaşlarıyla beraber dışarda eğlendiği esnada bir anda yere yığıldı. Acil olarak hastaneye kaldırılan Kane'in vücuduna sepsis (kan zehirlenmesi) yayıldığı belirtildi.

Genç adam, beş hafta boyunca sepsis hastalığıyla mücadele etti ve bu süre zarfında Newcastle'daki Freeman hastanesine nakledildi, burada suni komaya sokuldu ve iyileşme belirtileri gösterdi. Fakat enfeksiyon yeniden vücuduna yayılmaya başladı. Kane'in organları birer birer iflas etti ve genç adam hayatını kaybetti.

Dailymail'in haberine göre, annesi Rachel Kane, oğlunun tedavi süreci boyunca bir an bile yanından ayrılmadı. Cenaze öncesinde yerel basına konuşan anne, yaşadıklarını şöyle anlattı:
"O kadar güçlü bir çocuktu ki... Bir sinek ısırığının bunu yapabileceğini asla düşünmezdim. Her şey çok hızlı gelişti. Sonuna kadar yanındaydım. Hala gerçek gibi gelmiyor, sanki kötü bir rüya gibi..."